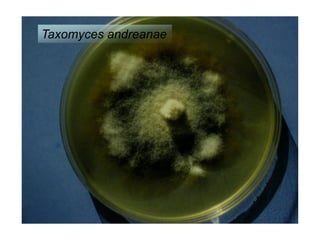
Taxomyces andreanae
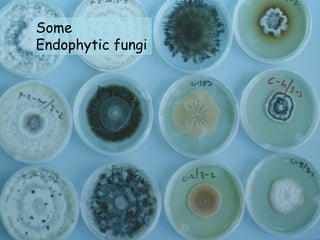
Some
Endophytic fungi
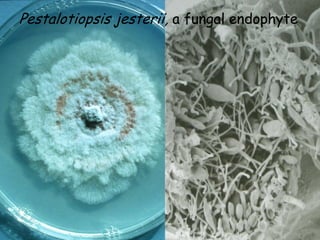
Pestalotiopsis jesterii, a fungal endophyte
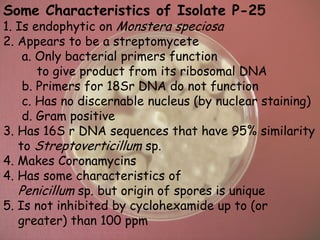
Some Characteristics of Isolate P-25
1. Is endophytic on Monstera speciosa
2. Appears to be a streptomycete
    a. Only bacterial primers function
       to give product from its ribosomal DNA
    b. Primers for 18Sr DNA do not function
    c. Has no discernable nucleus (by nuclear staining)
    d. Gram positive
3. Has 16S r DNA sequences that have 95% similarity
   to Streptoverticillum sp.
4. Makes Coronamycins
4. Has some characteristics of
   Penicillum sp. but origin of spores is unique
5. Is not inhibited by cyclohexamide up to (or
   greater) than 100 ppm
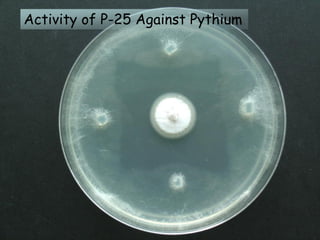
Activity of P-25 Against Pythium
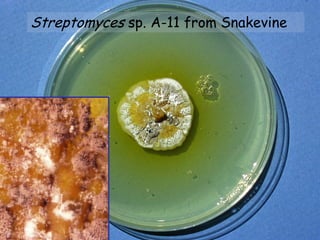
Streptomyces sp. A-11 from Snakevine
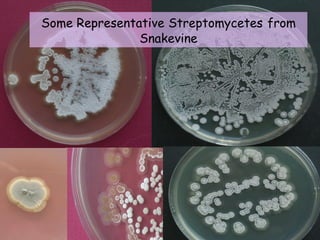
Some Representative Streptomycetes from
               Snakevine
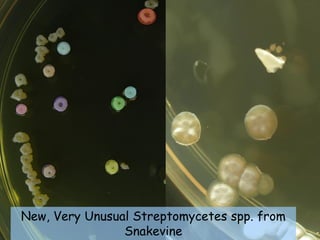
New, Very Unusual Streptomycetes spp. from
                Snakevine

The document discusses endophyte biology, particularly its applications in medicine and agriculture, highlighting the significance of plant biodiversity in isolating novel endophytes. Various studies on endophytic microbes, such as their defensive properties against pathogens and their potential medicinal uses, are presented, along with examples from diverse ecosystems. It emphasizes the importance of preserving rainforests due to the vast microbial diversity they harbor.